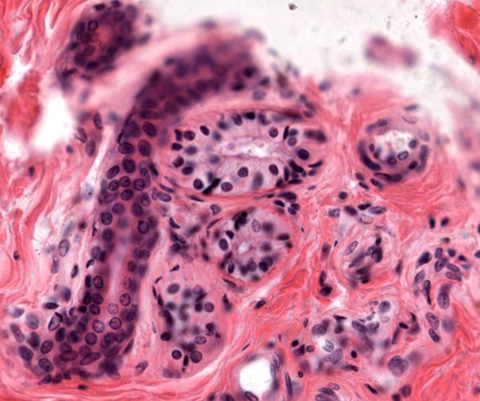

Skin Histology
Description: Histology and physiology skin appendages, glands, and receptors.
Skin Appendages, Glands, and Receptors
I. Appendages
§ Created through growth of the epidermis into the dermis
○ Pilosebaceous unit: hair follicle, arrector pilli muscle, and sebaceous gland
○ Nails
II. Pilosebaceous Unit
§ Created from invaginations of epidermis into the dermis, which is called the external root sheath
○ Surrounded by a thick basal lamina known as the glassy membrane
‒ Separates the hair follicle from the surrounding dermis
§ Hair root consists of
○ Central medulla (not present in medium to fine hair)
○ Cortex external to the medella,
○ Cuticle, outermost layer composed of a thin layer of heavily keratinized squamous cells
§ Cells that comprise the internal root sheath produce soft keratin

§ Base of hair follicle is comprised of proliferating keratinocytes
○ Highly vascular dermal papilla provide perfusion
○ Melanocytes present at the base provide melanin for hair pigment
○ Matrix keratinocytes produce keratin that hardens in the keratogenous zone of the shaft
§ Sebaceous glands secrete a waxy sebum into the hair follicle via short ducts
§ Arrector pili muscle (smooth muscle)
○ Runs obliquely from the hair follicle to the upper dermis
○ Contraction causes hairs to erect vertically
III. Nail
§ Nail plate forms over the dorsal surface of epidermis of digits in a region called the nail bed
§ Nail groove is formed from the invasion of the epidermis into the dermis along the transverse line
§ Nail plates are composed of keratinized epithelial cells that contain hard keratin
§ Nail matrix present under the nail root is the site where cells proliferate to generate cells that undergo keratinization to form the nail plate
○ This continuous process results in the nail advancing over the nail bed
§ Terms
○ Lunula: white, crescent shaped junction of the nail root with the nail plate
○ Eponychium (cuticle): cells from the stratum corneum that cover the nail root
○ Hyponychium: portion of the epidermis that is under the distal free end of the nail
IV. Glands
§ Three types
○ Sebaceous glands
○ Eccrine sweat glands
○ Apocrine sweat glands
V. Sebaceous Glands
§ Classified as simple branched acinar/alveolar exocrine glands
§ Located in the dermis, except in the glans penis, labia minora, and eyelids
§ Found in high density in the skin of the face, forehead, and scalp
§ Synthesize an oily substance called sebum via holocrine secretion
§ Histologically have round dense nuclei with clear cytoplasm

VI. Eccrine Sweat Glands
§ Simple, coiled tubular glands
§ Located in the dermis or hypodermis, especially in the palms and soles of feet
§ Merocrine secretion of sweat that is increased in response to sympathetic stimulation
○ Important for thermoregulation
§ Gland structure
○ Stratified cuboidal epithelium composed of both dark cells with rich ER (glycoproteins) and clear cells containing glycogen, water and electrolytes
○ Myoepithelial cells surround the gland and contract to help increase secretion of sweat
§ Duct structure
○ Stratified cuboidal epithelium with pale luminal cells and dark basal cells

VII. Apocrine Sweat Glands
§ Merocrine secretion of viscous secretion metabolized by bacteria on the skin surface contributing to body odor
○ Also secretes odiferous molecules (pheromones)
§ Located in the eyelid, axilla, areola of nipple, external genitalia, and anus
§ Gland composed of stratified cuboidal epithelium surrounded by myoepithelial cells
§ Stimulated by sympathetic stimulation
○ Function begin in puberty
§ Stratified cuboidal epithelium line their ducts which drain into upper part of hair follicles

VIII. Sensory Receptors
§ Mechanoreceptors: sense mechanical deformation or stress
○ Merkel (disks) corpuscles
○ Meissner’s corpuscles
○ Pacinian corpuscles
○ Ruffini corpuscles
§ Thermoreceptors: sense temperature changes
§ Nociceptors: sense pain that can be caused by excessive touch, pressure, or temperature
IX. Merkel’s Corpuscle
§ Merkel’s cells are nerve endings of unmyelinated axons
§ Found in the stratum basale layer
§ Mechanoreceptors for touch
X. Meissner’s Corpuscle
§ Encapsulated afferent nerve endings
§ Located in dermal papillae at epidermis-dermis junction
§ Highly sensitive tactile receptors
§ Schwann cells create a swirled appearance


XI. Pacinian Corpuscle
§ Large, multilayered, encapsulated nerve ending of myelinated axons
○ Onion appearance due to fluid between endoneurial and capsular layers
§ Found in the deep dermis and hypodermis
§ Sense sustained pressure and vibration
XII. Ruffini Corpuscle
§ Small, encapsulated nerve endings of single myelinated axons
§ Sense sustained stretching

